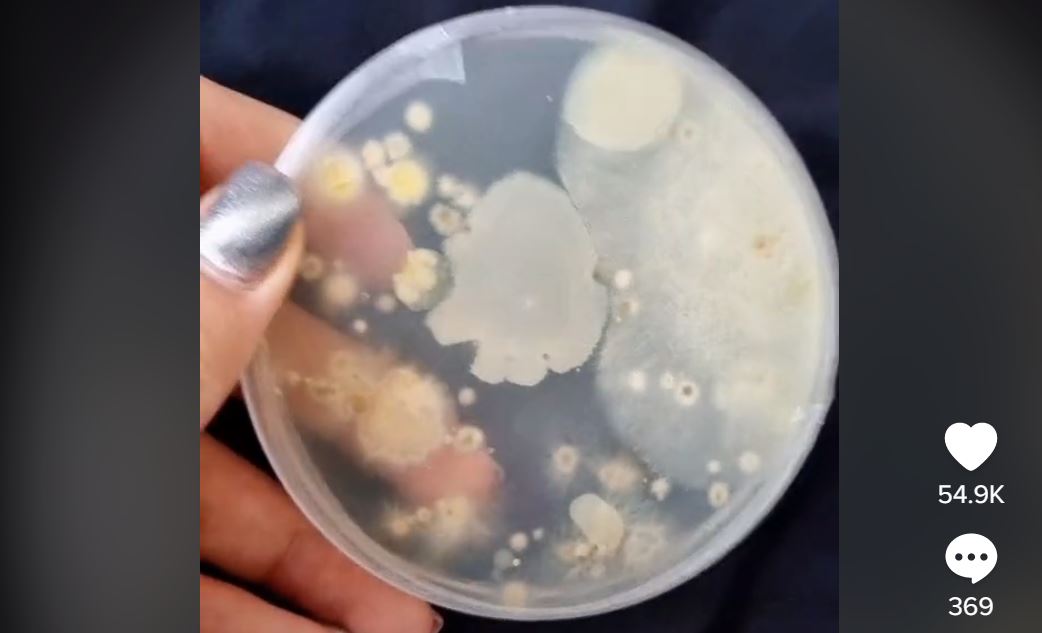

Soha többé nem nyúlsz jegyautomatához, ha ezt megnézed: hemzsegnek a kórokozók a kijelzőn!
A növényorvos mintát vett egy BKK jegykiadó érintőképernyőjéről, majd kitenyésztette, amit talált. Pár nap múlva alig hitt a szemének!
A növényorvos mintát vett egy BKK jegykiadó érintőképernyőjéről, majd kitenyésztette, amit talált. Pár nap múlva alig hitt a szemének!
A növényorvos mintát vett egy BKK jegykiadó érintőképernyőjéről, majd kitenyésztette, amit talált. Pár nap múlva alig hitt a szemének!
Te se tapicskolod többé jó szívvel a jegykiadó automaták képernyőjét, ha megnézed mi minden burjánzik rajta!
Gyuris Rita, a MATE Kertészettudományi Doktori Iskola növényorvosa a Plantprotecting Rita TikTok-csatornán osztotta meg a fakultatív kutatás eredményét.
Forrás: Plantprotecting Rita
Szakszerű mintavétel és Petri-csészés tenyésztés után 1-2-3 nappal is készített felvételt a táptalajon kiválasztódó baktérium- és gombatelepekről. Hát, ilyen:
@plantprotecting Visszatértem.. 😁 BKK automata teszt #baktérium #gomba #teszt #agarlemez #kísérlet
Nem csak COVID-járvány alatt érdemes tehát kézfertőtlenítő spray-vel mászkálni! Ha akarsz egy napi jócselekedetet, ne csak a kezedre, néha a kijelzőre is fúj belőle, mert az üzemeltető láthatóan nem tépi magát, hogy tisztán tartsa. Rita egyébként egy kommentre reagálva megjegyezte, hogy tervben van a bevásárlókocsi fogójának vizsgálata is. Az még szép lesz!
https://leetgaming.com/2022/08/28/szoktal-dobozos-uditot-inni-ennyi-es-ilyen-korokozo-van-a-szajreszenel/
